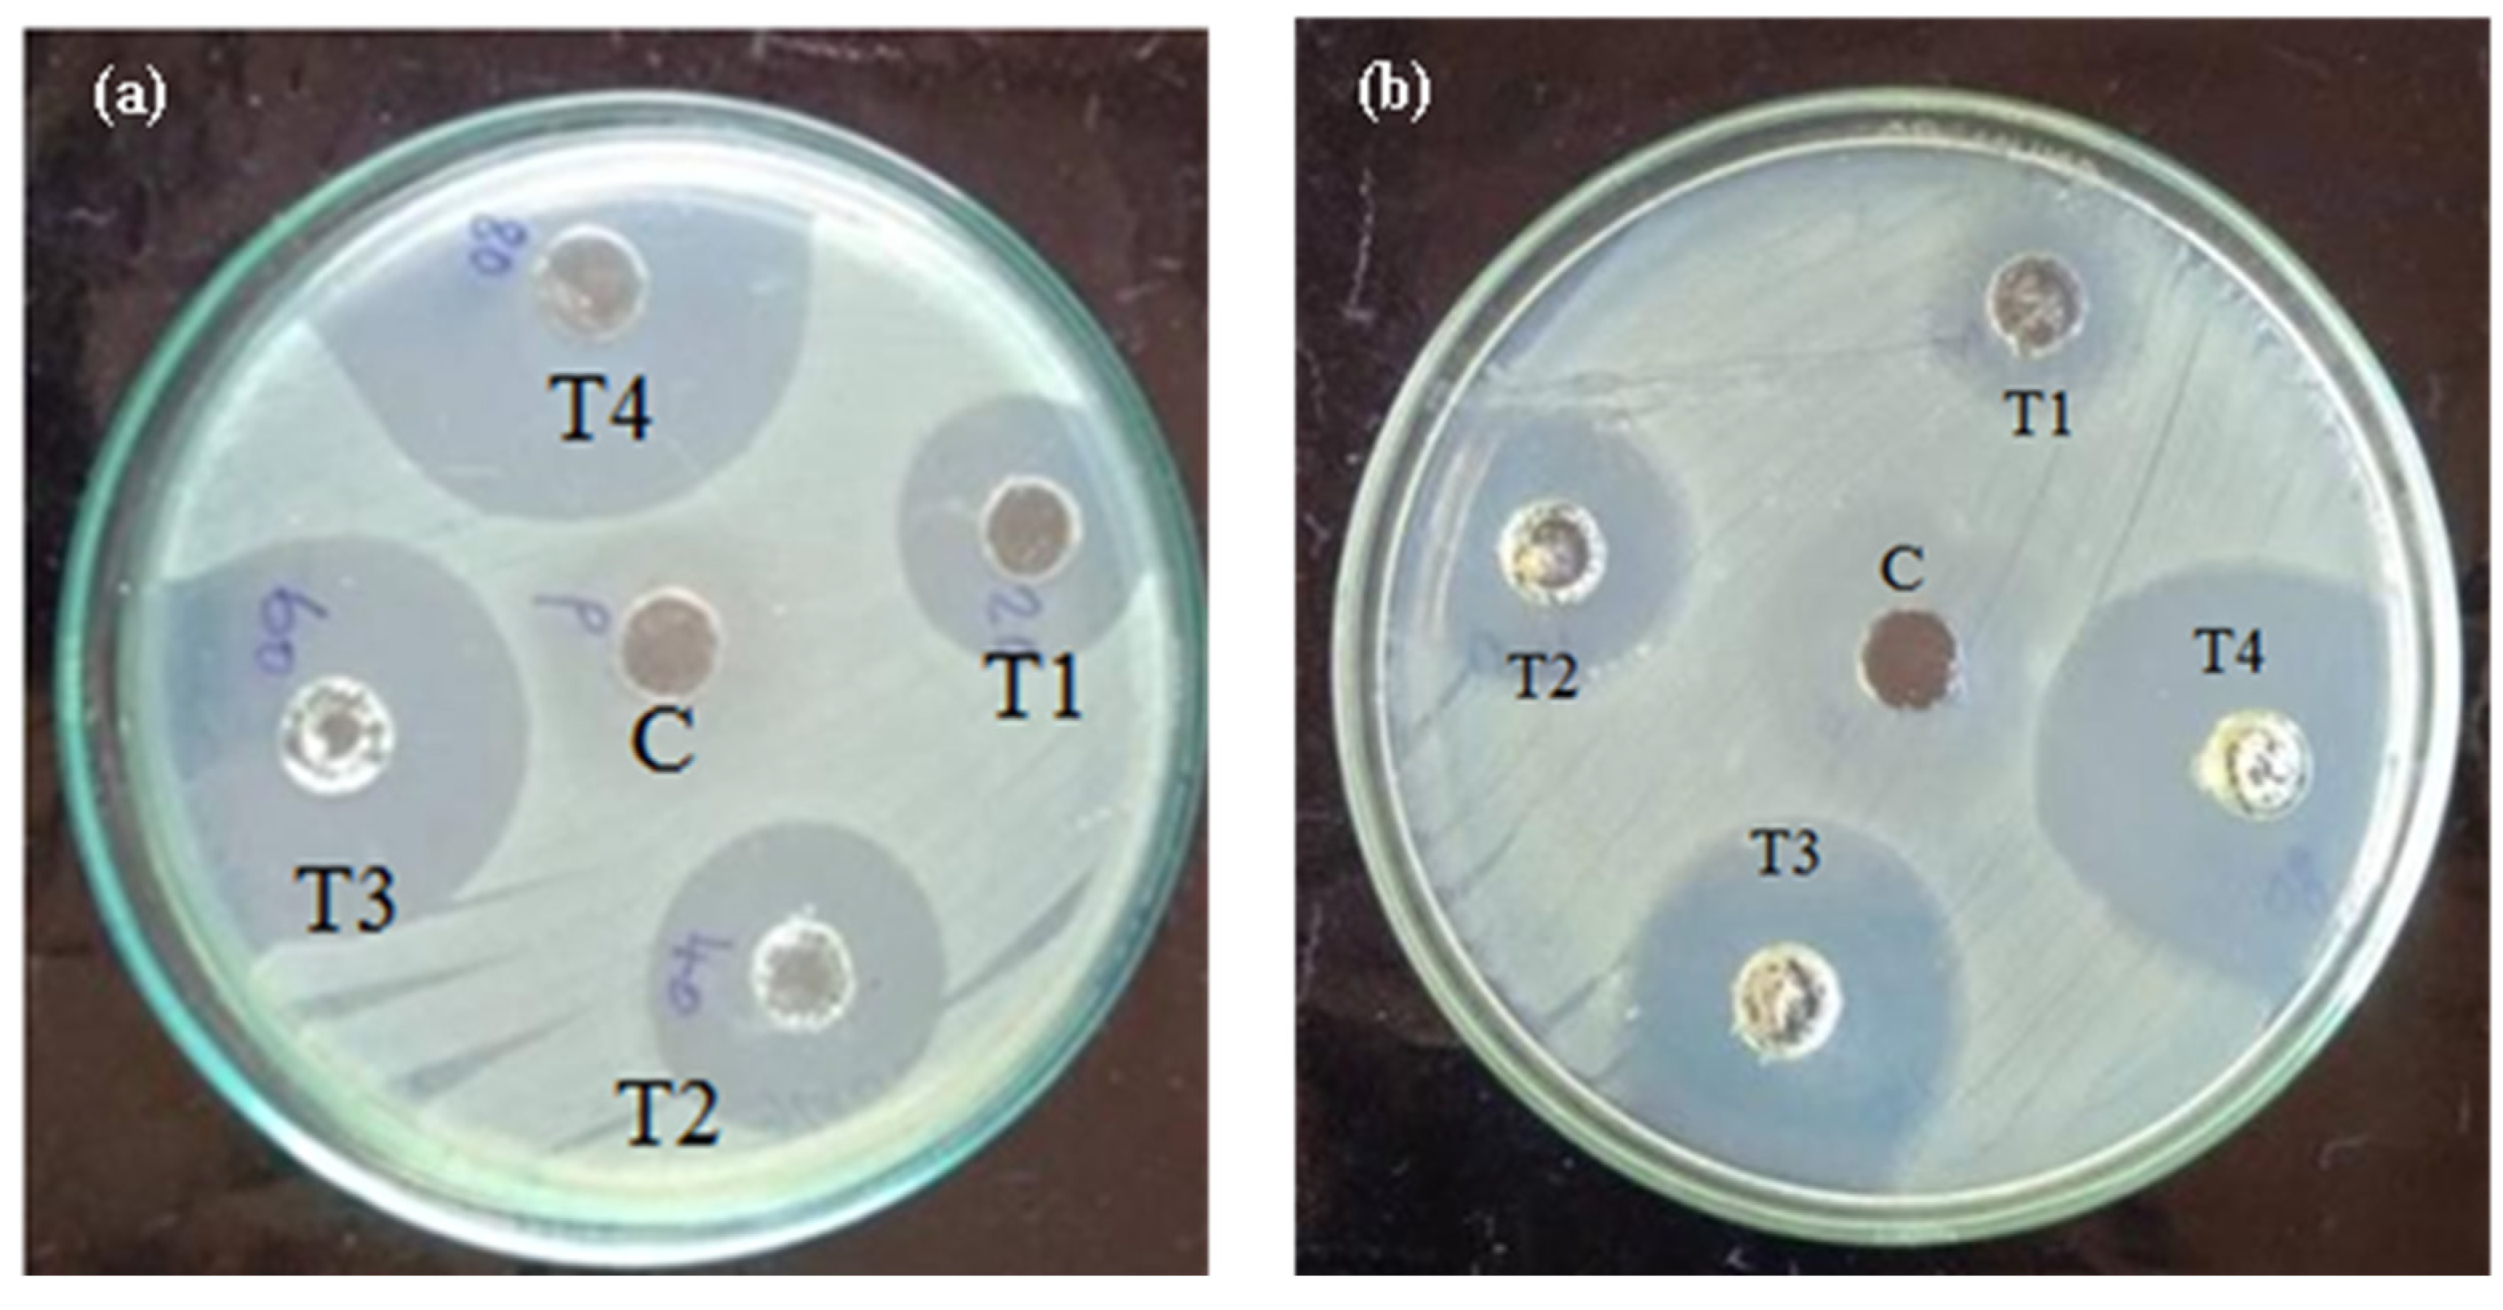
Biomedicines 11 01690 g005

Synthesis and Characterization of Mithun (Bos frontalis) Urine-Based Antibacterial Copper Oxide Nanoparticles
Abstract
1. Introduction
2. Materials and Methods
2.1. Chemicals
2.2. Collection of Mithun Urine
2.3. Preparation of MU-CuO NPs
2.4. Microorganisms
2.5. Characterization of Synthesized MU-CuO NPs
2.6. Antibacterial Activity
2.7. Statistical Analysis
3. Results
3.1. UV-Visible Spectroscopic Analysis
3.2. Fourier Transform Infrared Spectroscopic Analysis
3.3. Scanning Electron Microscopic Analysis
3.4. X-ray Diffraction Analysis
3.5. Antibacterial Analysis
4. Discussion
5. Conclusions
Author Contributions
Funding
Institutional Review Board Statement
Informed Consent Statement
Data Availability Statement
Acknowledgments
Conflicts of Interest
References
- El-Sayed Ali, T.; Abdel-Aziz, S.H.; El-Sayed, A.M.; Zeid, S. Structural and functional effects of early exposure to 4-nonylphenol on gonadal development of Nile tilapia (Oreochromis niloticus): A-histological alterations in ovaries. Fish Physiol. Biochem. 2014, 40, 1509–1519. [Google Scholar] [CrossRef]
- Sattanathan, G.; Liu, W.C.; Padmapriya, S.S.; Pushparaj, K.; Sureshkumar, S.; Lee, J.W.; Balasubramanian, B. Effects of dietary blend of algae extract supplementation on growth, biochemical, haemato-immunological responses, and immune gene experssions in Labeo rohita with Aeromonas hydrophila post challenges. Fishes 2023, 8, 7. [Google Scholar] [CrossRef]
- El-Sayed Ali, T.; El-Sayed, A.M.; Abdel-Razek Eissa, M.; Hanafi, H. Effects of dietary biogen and sodiumbutyrate on hematological parameters, immune response and histological characteristics of Nile tilapia(Oreochromis niloticus) fingerlings. Aquac. Int. 2017, 26, 139–150. [Google Scholar] [CrossRef]
- Karthika, V.; Kaleeswarran, P.; Gopinath, K.; Arumugam, A.; Govindarajan, M.; Alharbi, N.S.; Khaled, J.M.; Al-anbr, M.N.; Benelli, G. Biocompatible properties of nano-drug carriers using TiO2-Au embedded on multiwall carbon nanotubes for targeted drug delivery. Mater. Sci. Eng. C 2018, 90, 589–601. [Google Scholar] [CrossRef]
- Kolanjinathan, K.; Ganesh, P.; Govindarajan, M. Antibacterial activity of ethanol extracts of seaweeds against fish bacterial pathogens. Eur. Rev. Med. Pharmacol. Sci. 2009, 13, 173–177. [Google Scholar] [PubMed]
- Rice, L.B. The clinical consequences of antimicrobial resistance. Curr. Opin. Microbiol. 2009, 12, 476–481. [Google Scholar] [CrossRef] [PubMed]
- Hektoen, H.; Berge, J.A.; Hormazabal, V.Y.; Yndestad, M. Persistence of antibacterial agents in marine sediments. Aquaculture 1995, 133, 175–184. [Google Scholar] [CrossRef]
- Cabello, F.C. Heavy use of prophylactic antibiotics in aquaculture: A growing problem for human and animal health and for theenvironment. Environ. Microbiol. 2006, 8, 1137–1144. [Google Scholar] [CrossRef]
- Novotny, L.; Dvorska, L.; Lorencova, A.; Beran, V.; Pavlik, I. Fish: A potential source of bacterial pathogens for human beings. Vet. Med. Czech 2004, 9, 343–358. [Google Scholar] [CrossRef]
- Tenover, F.C. Mechanisms of antimicrobial resistance in bacteria. Am. J. Infect. Control 2006, 34, S3–S10. [Google Scholar] [CrossRef] [PubMed]
- Kaplan, O.; Tosun, N.G.; Ozgür, A.; Tayhan, S.E.; Bilgin, S.; Türkekul, I.; Gokce, I. Microwave-assisted green synthesis of silver nanoparticles using crude extracts of Boletus edulis and Coriolus versicolor: Characterization, anticancer, antimicrobial and wound healing activities. J. Drug Deliv. Sci. Technol. 2021, 64, 10264. [Google Scholar] [CrossRef]
- Panacek, A.; Kvitek, L.; Prucek, R.; Kolar, M.; Vecerova, V.; Pizurova, N.; Sharma, V.; Nevecna, T.; Zboril, R. Silver Colloid Nanoparticles: Synthesis, Characterization, and Their Antibacterial Activity. J. Phys. Chem. B 2006, 110, 16248–16253. [Google Scholar] [CrossRef]
- Chen, X.; Schluesener, H.J. Nanosilver: A Nanoproduct in Medical Application. Toxicol. Lett. 2008, 176, 1–12. [Google Scholar] [CrossRef]
- Ishwarya, R.; Vaseeharan, B.; Anuradha, R.; Rekha, R.; Govindarajan, M.; Alharbi, N.S.; Kadaikunnan, S.; Khaled, J.M.; Benelli, G. Eco-friendly fabrication of Ag nanostructures using the seed extract of Pedalium murex, an ancient indian medicinal plant: Histopathological effects on the zika virus vector Aedes aegypti and inhibition of biofilm-forming pathogenic bacteria. J. Photochem. Photobiol. B Biol. 2017, 174, 133–143. [Google Scholar] [CrossRef]
- Banumathi, B.; Vaseeharan, B.; Ishwarya, R.; Govindarajan, M.; Alharbi, N.S.; Kadaikunnan, S.; Khaled, J.M.; Benelli, G. Toxicity of herbal extracts used in ethno-veterinary medicine and green-encapsulated ZnO nanoparticles against Aedes aegypti and microbial pathogens. Parasitol. Res. 2017, 116, 1637–1651. [Google Scholar] [CrossRef] [PubMed]
- Iswarya, A.; Vaseeharan, B.; Anjugam, M.; Ashokkumar, B.; Govindarajan, M.; Alharbi, N.S.; Kadaikunnan, S.; Khaled, J.M.; Benelli, G. Multipurpose efficacy of ZnO nanoparticles coated by the crustacean immune molecule β-1, 3-glucan binding protein: Toxicity on HepG2 liver cancer cells and bacterial pathogens. Colloids Surf. B Biointerfaces 2017, 158, 257–269. [Google Scholar] [CrossRef] [PubMed]
- Karthika, V.; AlSalhi, M.S.; Devanesan, S.; Gopinath, K.; Arumugam, A.; Govindarajan, M. Chitosan overlaid Fe3O4/rGO nanocomposite for targeted drug delivery, imaging, and biomedical applications. Sci. Rep. 2020, 10, 18912. [Google Scholar] [CrossRef] [PubMed]
- Acharyulu, N.P.S.; Dubey, R.S.; Swaminadham, V.; Pratap, K.; Kalyani, R.L.; Pammi, S.V.N. Green synthesis of CuO nanoparticles using Phyllanthus amarus leaf extract and their antibacterial activity against multidrug resistance bacteria. Int. J. Eng. Res. Technol. 2014, 3, 639–641. [Google Scholar]
- Sahooli, M.; Sabbaghi, S.; Saboori, R. Synthesis and characterization of mono sized CuO nanoparticles. Mater. Lett. 2012, 81, 169–172. [Google Scholar] [CrossRef]
- Soltanianfard, M.J.; Firoozadeh, A. Synthesis and characterization of copper(II)-oxide nanoparticles from two Cu(II) coordination polymers. J. Sci. Islam. Repub. Iran 2016, 27, 113–117. [Google Scholar]
- Radhakrishnan, A.A.; Beena, B.B. Structural and optical absorption analysis of CuO nanoparticles. Indian J. Adv. Chem. Sci. 2014, 2, 158–161. [Google Scholar]
- Dar, M.A.; Kim, Y.S.; Kim, W.B.; Sohn, J.M.; Shin, H.S. Structural and magnetic properties of CuO nanoneedles synthesized by hydrothermal method. Appl. Surf. Sci. 2008, 254, 7477–7481. [Google Scholar] [CrossRef]
- Dang, T.M.D.; Le, T.T.T.; Fribourg-Blanc, E.; Dang, M.C. Synthesis and optical properties of copper nanoparticles prepared by a chemical reduction method. Adv. Nat. Sci. Nanosci. Nanotechnol. 2011, 2, 015009. [Google Scholar] [CrossRef]
- Sundaramurthy, N.; Parthiban, C. Biosynthesis of copper oxide nanoparticles using Pyrus pyrifolia leaf extract and evolve thecatalytic activity. Int. Res. J. Eng. Technol. 2015, 2, 332–338. [Google Scholar]
- Dastjerdi, R.; Montazer, M. A review on the application of inorganic nano-structured materials in the modification of textiles: Focus on antimicrobial properties. Colloids Surf. B Biointerfaces 2010, 79, 5–18. [Google Scholar] [CrossRef]
- Sattanathan, G.; Venkatalalkshmi, S. Application of Cow Urine Distillate for Enhancement of Nutrient Value and Water Quality of Indian Major Carp, Labeo rohita (Hamilton) Fingerlings. LS Int. J. Life Sci. 2016, 5, 1–8. [Google Scholar] [CrossRef]
- Sattanathan, G.; Rajesh, R. Antibacterial activity of extract of Chaetomorpha aerea against fish pathogens. Ecol. Fish. 2013, 7, 9–14. [Google Scholar]
- Yougbaré, S.; Mutalik, C.; Okoro, G.; Lin, I.H.; Krisnawati, D.I.; Jazidie, A.; Nuh, M.; Chang, C.C.; Kuo, T.R. Emerging Trends in Nanomaterials for Antibacterial Applications. Int. J. Nanomed. 2021, 26, 5831–5867. [Google Scholar] [CrossRef]
- Cappuccinno, J.G.; Sherman, N. Micro a Laboratory Manual; Addison Wesley Longman Inc.: Reading, MA, USA, 1999; pp. 254–256. [Google Scholar]
- Roszek, B.; De Jong, W.H.; Geertsma, R.E. Nanotechnology in Medical Applications: State-of-the-Art in Materials and Devices; RIVM report 265001001/2005; Rijksinstituut voor Volksgezondheid en Milieu RIVM: Bilthoven, The Netherlands, 2005; pp. 1–123. [Google Scholar]
- Bouwmeester, H.; Dekkers, S.; Noordam, M.; Hagens, W.; Bulder, A.; De Heer, C.; Ten Voorde, S.; Wijnhoven, S.; Sips, A. Health Impact of Nanotechnologies in Food Production; Wageningen UR, RIKILT. Report 2007.014; RIKILT—Institute of Food Safety, Wageningen UR: Wageningen, The Netherlands; National Institute of Public Health & the Environment—Center for Substances and Integrated Risk Assessment: Bilthoven, The Netherlands, 2007; pp. 1–91. Available online: http://edepot.wur.nl/120669 (accessed on 11 May 2022).
- Kiruba Daniel, S.C.G.; Vinothini, G.; Subramanian, N.; Nehru, K.; Sivakumar, M. Biosynthesis of Cu, ZVI, and Ag nanoparticles using Dodonaea viscosa extract for antibacterial activity against human pathogens. J. Nanopart. Res. 2013, 15, 1319–1328. [Google Scholar] [CrossRef]
- Feynman, R. There’s plenty of room at the bottom. Science 1991, 254, 1300–1301. [Google Scholar]
- Rai, V.R.; Bai, A.J. Nanoparticles and their potential application as antimicrobials. In Science against Microbial Pathogens: Communicating Current Research and Technological Advances; Mendez-Vilas, A., Ed.; Formatex Res Center Spain: Badajoz, Spain, 2011; Volume 1, pp. 197–209. [Google Scholar]
- Verma, V. Fungus disease in fish, diagnosis and treatment. Vet. World 2008, 1, 62. [Google Scholar]
- Carbis, C.R.; Mitchell, G.F.; Anderson, J.W.; McCauley, I. The effects of microcystins on the serum biochemistry of carp, Cyprinus carpio L., when the toxins are administered by gavage, immersion and intraperitoneal routes. J. Fish Dis. 1996, 19, 151–159. [Google Scholar] [CrossRef]
- Fischer, W.J.; Hitzfeld, B.C.; Tencalla, F.; Eriksson, J.E.; Mikhailov, A.; Dietrich, D.R. Microcystin-LR toxicodynamics, induced pathology and immunohistochemical localization in livers of blue–green algae exposed rainbow trout (Oncorhynchus mykiss). Toxicol. Sci. 2000, 54, 365–373. [Google Scholar] [CrossRef] [PubMed]
- Malbrouck, C.; Kestemont, P. Effects of microcystins on fish. Environ. Toxicol. Chem. 2006, 25, 72–86. [Google Scholar] [CrossRef] [PubMed]
- Ernst, B. Investigations of the Impact of Toxic Cyanobacteria on Fishas Exemplified by the Coregonids in Lake Ammersee. Ph.D. Thesis, University of Kostanz, Konstanz, Germany, 2008. [Google Scholar]
- Sattanathan, G.; Tamizhazhagan, V.; Raza, N.; Shah, S.Q.A.; Hussain, M.Z.; Kim, K.H. Effects of Green Alga, Chaetomorpha aerea Extract on Non-Specific Immune Responses and Disease Resistance against Edwardsiella tarda Infection in Labeo rohita. Appl. Sci. 2021, 11, 4325. [Google Scholar] [CrossRef]
- Sattanathan, G.; Padmapriya, S.S. Biochemical composition of Siganus lineatus (Valencennes, 1835) from Parangipettai, South East Coast of Tamilnadu, India. Indian J. Nat. Sci. 2021, 12, 30282–30287. [Google Scholar]
- Sattanathan, G.; Shyamala, V.; Deepa, B.; Keerthiga, R. Dietary administration of Pleurotus sajor caju mushroom extract on Growth, Immune Response and Disease Resistance in Gibelion catla against Aeromonas hydrophila. LS Int. J. Life Sci. 2018, 7, 142–150. [Google Scholar] [CrossRef]
- Hu, X.; Kandasamy, S.T.J.; Wang, M.H. Mycosynthesis, characterization, anticancer and antibacterial activity of silver nanoparticles from endophytic fungus Talaromyces purpureogenus. Int. J. Nanomed. 2019, 14, 3427. [Google Scholar] [CrossRef]
- Shaheen, M.N.; El-hadedy, D.E.; Ali, Z.I. Medical and microbial applications of controlled shape of silver nanoparticles prepared by ionizing radiation. BioNanoScience 2019, 9, 414–422. [Google Scholar] [CrossRef]
- Arunachalam, K.D.; Arun, L.B.; Annamalai, S.K.; Arunachalam, A.M. Potential anticancer properties of bioactive compounds of Gymnema sylvestre and its biofunctionalized silver nanoparticles. Int. J. Nanomed. 2015, 10, 31–41. [Google Scholar] [CrossRef]
- Manikandan, R.; Anjali, R.; Beulaja, M.; Prabhu, N.M.; Koodalingam, A.; Saiprasad, G.; Chitra, P.; Arumugam, M. Synthesis, characterization, anti-proliferative and wound healing activities of silver nanoparticles synthesized from Caulerpascalpelli-formis. Process Biochem. 2019, 79, 135–141. [Google Scholar] [CrossRef]
- Santhosh, A.S.; Sandeep, S.; Manukumar, H.M.; Mahesh, B.; Kumara Swamy, N. Green synthesis of silver nanoparticles using cow urine: Antimicrobial and blood biocompatibility studies. JCIS Open 2021, 3, 100023. [Google Scholar] [CrossRef]
- Saravanakumar, K.; Shanmugam, S.; Varukattu, N.B.; MubarakAli, D.; Kathiresan, K.; Wang, M.H. Biosynthesis and characterization of copper oxide nanoparticles from indigenous fungi and its efect of photothermolysis on human lung carcinoma. J. Photochem. Photobiol. B 2019, 190, 103–109. [Google Scholar] [CrossRef]
- Baek, Y.; An, Y. Microbial toxicity of metal oxide nanoparticles (CuO, NiO, ZnO, and Sb2O3) to Escherichia coli, Bacillus subtilis and Streptococcus aureus. Sci. Total Environ. 2011, 409, 1603–1608. [Google Scholar] [CrossRef]
- Azam, A.; Ahmed, A.S.; Oves, M.; Khan, M.S.; Habib, S.S.; Memic, A. Antimicrobial activity of metal oxide nanoparticles against Gram-positive and Gram-negative bacteria: A comparative study. Int. J. Nanomed. 2012, 7, 6003. [Google Scholar] [CrossRef]
- Abboud, Y.; Saffaj, T.; Chagraoui, A.; El Bouari, A.; Brouzi, K.; Tanane, O.; Ihssane, B. Biosynthesis, characterization and antimicrobial activity of copper oxide nanoparticles (CONPs) produced using brown alga extract (Bifurcaria bifurcata). Appl. Nanosci. 2014, 4, 571–576. [Google Scholar] [CrossRef]
- Sihail, M.F.; Rehman, M.; Hussain, S.Z.; Huma, Z.; Shahnaz, G.; Qureshi, O.S.; Khalid, Q.; Mirsa, S.; Hussain, I.; Webstar, T.J. Green synthesis of zinc, copper oxide nanoparticles by neem extract as multi-facet therapeutic agents. J. Drug Deliv. Sci. Technol. 2020, 59, 101911. [Google Scholar] [CrossRef]
- Wu, B.; Huang, R.; Sahu, M.; Feng, X.; Biswas, P.; Tang, Y.J. Bacterial responses to Cu-doped TiO2 nanoparticles. Sci. Total Environ. 2010, 408, 1755–1758. [Google Scholar] [CrossRef] [PubMed]
- Sattanathan, G.; Thanapal, G.; Swaminathan, S.; Kim, H.; Vijaya, R.; Kim, H.; Balasubramanian, B. Influences of dietary inclusion of algae Chaetomporpha aerea enhanced growth performance, immunity, haematological response and disease resistance of Labeo rohita challenged with Aeromonas hydrophila. Aquac. Rep. 2020, 17, 100353. [Google Scholar] [CrossRef]
- Sattanathan, G.; Tamizhazhagan, V.; Padmapriya, S.; Liu, W.C.; Balasubramanian, B. Effect of Green Algae Chaetomorpha antennina Extract on Growth, Modulate Immunity, and Defenses against Edwardsiella tarda Infection in Labeo rohita. Animals 2020, 10, 2033. [Google Scholar] [CrossRef] [PubMed]
- Sumathy, R.; Babujanarthanam, R. Formulation and Evaluation of Biodegradable Sustained Release Aceprophyline Cow Urine Nanoparticle for the Treatment of Asthma. J. Biosci. 2015, 2, 120–124. [Google Scholar]
- Prabhu, M.; Mutnuri, S.; Dubey, S.K.; Naik, M.M. One-Pot Rapid Synthesis of Face-Centered Cubic Silver Nanoparticles Using Fermented Cow Urine, a Nanoweapon against Fungal and Bacterial Pathogens. J. Bionanosci. 2014, 8, 265–273. [Google Scholar] [CrossRef]
- Jain, N.; Bhosale, P.; Tale, V.; Henry, R.; Pawar, J. Hydrothermal assisted biological synthesis of silver nanoparticles by using honey and gomutra (Cow Urine) for qualitative determination of its antibacterial efficacy against Pseudomonas sp. isolated from contact lenses. EurAsian J. BioSci. 2019, 13, 27–33. [Google Scholar]
- Govarthanan, M.; Selvankumar, T.; Manoharan, K.; Rathika, R.; Shanthi, K.; Lee, K.J. Biosynthesis and characterization of silver nanoparticles using panchakavya, an Indian traditional farming formulating agent. Int. J. Nanomed. 2014, 9, 1593–1599. [Google Scholar] [CrossRef] [PubMed]
- Arumugam, D.G.; Sivaji, S.; Dhandapani, K.V.; Nookala, S.; Ranganathan, B. Panchagavya mediated copper nanoparticles synthesis, characterization and evaluating cytotoxicity in brine shrimp. Biocatal. Agric. Biotechnol. 2019, 19, 101132. [Google Scholar] [CrossRef]
- Vinay, S.; Udayabhanu, N.G.; Chandrappa, C.P.; Chandrasekhar, N. Novel Gomutra (cow urine) mediated synthesis of silver oxide nanoparticles and their enhanced photocatalytic, photoluminescence and antibacterial studies. J. Sci. Adv. Mater. Devices 2019, 4, 392–399. [Google Scholar] [CrossRef]
- Nazeruddin, G.M.; Shaikh, Y.I.; Prasad, S.R.; Prasad, N.R.; Attar, Y.A.; Patil, P.S. Bos taurus Urine Assisted Synthesis of Cadmium Nanoparticles. Der Pharma Chem. 2017, 9, 39–43. [Google Scholar]
- Suk, K.H.; Gopinath, S.C.B.; Anbu, P.; Lakshmipriya, T. Cellulose nanoparticles encapsulated cow urine for effective inhibition of pathogens. Powder Technol. 2018, 328, 140–147. [Google Scholar] [CrossRef]
- Satheeshkumar, M.K.; Ranjith Kumar, E.; Srinivas, C.; Prasad, G.; Meena, S.S.; Pradeep, I. Structural and magnetic properties of CuFe2O4 ferrite nanoparticles synthesized by cow urine assisted combustion method. J. Magn. Magn. Mater. 2019, 484, 120–125. [Google Scholar] [CrossRef]
- Chamoli, P.; Srivastava, T.; Tyagi, A.; Raina, K.K.; Kar, K.K. Urea and cow urine-based green approach to fabricate graphene-based transparent conductive films with high conductivity and transparency. Mater. Chem. Phys. 2020, 242, 122465. [Google Scholar] [CrossRef]
- Prasad, S.R.; Padvi, M.N.; Suryawanshi, S.S.; Shaikh, Y.I.; Chaudhary, L.S.; Samant, A.P. Bio-inspired synthesis of catalytically and biologically active palladium nanoparticles using Bos taurus urine. SN Appl. Sci. 2020, 2, 754. [Google Scholar] [CrossRef]

Disclaimer/Publisher’s Note: The statements, opinions and data contained in all publications are solely those of the individual author(s) and contributor(s) and not of MDPI and/or the editor(s). MDPI and/or the editor(s) disclaim responsibility for any injury to people or property resulting from any ideas, methods, instructions or products referred to in the content. |
© 2023 by the authors. Licensee MDPI, Basel, Switzerland. This article is an open access article distributed under the terms and conditions of the Creative Commons Attribution (CC BY) license (https://creativecommons.org/licenses/by/4.0/).
Share and Cite
Pelesinuo, K.B.; Sattanathan, G.; Haque, N.; Al-Ghanim, K.A.; Nicoletti, M.; Sachivkina, N.; Govindarajan, M. Synthesis and Characterization of Mithun (Bos frontalis) Urine-Based Antibacterial Copper Oxide Nanoparticles. Biomedicines 2023, 11, 1690. https://doi.org/10.3390/biomedicines11061690
Pelesinuo KB, Sattanathan G, Haque N, Al-Ghanim KA, Nicoletti M, Sachivkina N, Govindarajan M. Synthesis and Characterization of Mithun (Bos frontalis) Urine-Based Antibacterial Copper Oxide Nanoparticles. Biomedicines. 2023; 11(6):1690. https://doi.org/10.3390/biomedicines11061690
Chicago/Turabian StylePelesinuo, Khriebu Bizo, Govindharajan Sattanathan, Nazrul Haque, Khalid A. Al-Ghanim, Marcello Nicoletti, Nadezhda Sachivkina, and Marimuthu Govindarajan. 2023. "Synthesis and Characterization of Mithun (Bos frontalis) Urine-Based Antibacterial Copper Oxide Nanoparticles" Biomedicines 11, no. 6: 1690. https://doi.org/10.3390/biomedicines11061690
APA StylePelesinuo, K. B., Sattanathan, G., Haque, N., Al-Ghanim, K. A., Nicoletti, M., Sachivkina, N., & Govindarajan, M. (2023). Synthesis and Characterization of Mithun (Bos frontalis) Urine-Based Antibacterial Copper Oxide Nanoparticles. Biomedicines, 11(6), 1690. https://doi.org/10.3390/biomedicines11061690

